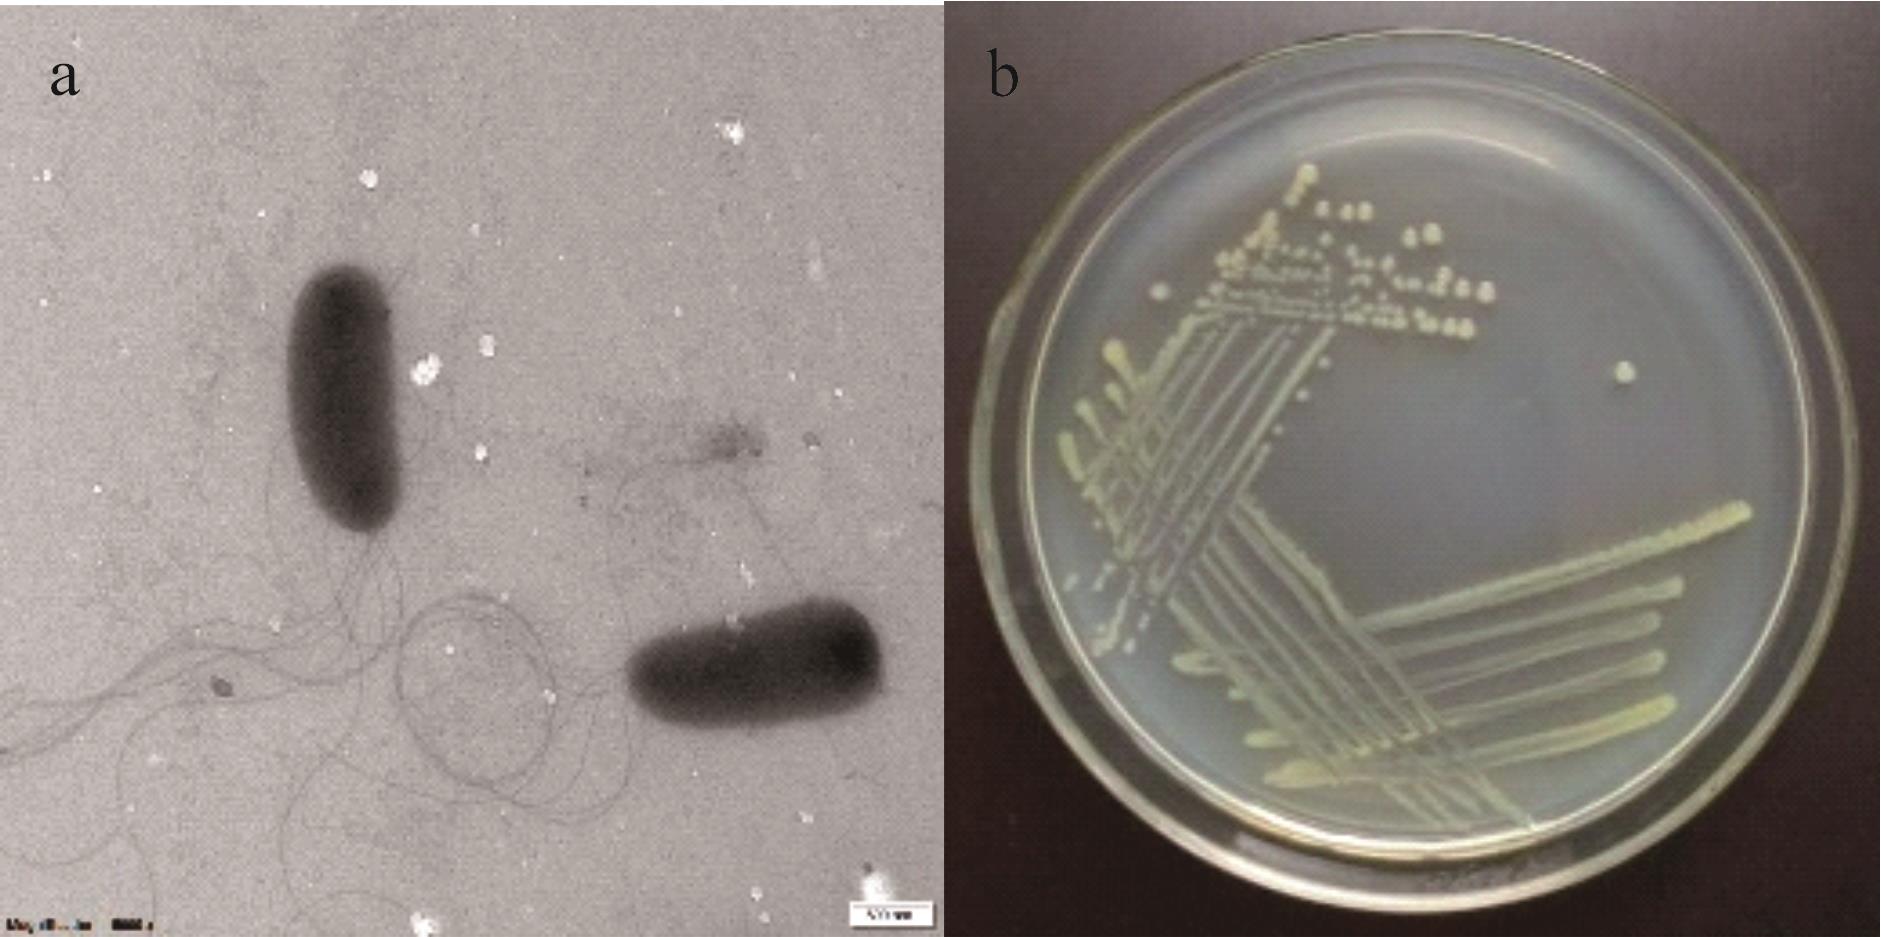

ISSN 1004-5759 CN 62-1105/S


草业学报 ›› 2025, Vol. 34 ›› Issue (11): 53-65.DOI: 10.11686/cyxb2024497
李春艳1,2( ), 王钱进1,2, 周芯合1, 曹文静1, 赵梦丽1,2, 虞方伯1,2(
), 王钱进1,2, 周芯合1, 曹文静1, 赵梦丽1,2, 虞方伯1,2( )
)
收稿日期:2024-12-19
修回日期:2025-02-17
出版日期:2025-11-20
发布日期:2025-10-09
通讯作者:
虞方伯
作者简介:E-mail: yufangbo@aliyun.com基金资助:
Chun-yan LI1,2( ), Qian-jin WANG1,2, Xin-he ZHOU1, Wen-jing CAO1, Meng-li ZHAO1,2, Fang-bo YU1,2(
), Qian-jin WANG1,2, Xin-he ZHOU1, Wen-jing CAO1, Meng-li ZHAO1,2, Fang-bo YU1,2( )
)
Received:2024-12-19
Revised:2025-02-17
Online:2025-11-20
Published:2025-10-09
Contact:
Fang-bo YU
摘要:
为了应对我国耕地质量下降现状,丰富生物改良技术手段,研发应用微生物菌剂具有重要意义。以伯克霍尔德氏菌属SX9为供试菌株,研究其促生特性,并通过盆栽试验对比不同浓度菌剂(T1~T3处理)、培养液(T4~T6处理),以及纯水(CK)对白三叶生长、根际土壤理化性质以及微生物群落的影响。结果显示,Burkholderia sp. SX9具备产纤维素分解酶、蛋白酶和氨等多种促生特性;Burkholderia sp. SX9菌剂能够促进白三叶生长,相较CK和T4处理,T1处理(菌剂原液)白三叶可溶性糖含量显著增加60.56%和31.26%,可溶性蛋白含量显著增加43.32%和15.52%,根系增长20.31%和5.48%;种植白三叶能够改善根际土壤酸碱环境;T1处理有利于电导率提升,相较T4处理,有效磷和速效钾含量分别增加27.22%和9.27%;T1和T2处理加速了土壤有机质分解,T1与T4相比和T2与T5相比,含量分别降低5.23%和2.07%。Alpha多样性分析显示,T1处理显著降低了根际土壤中真菌和细菌的丰富度、多样性和均匀度。高通量测序分析显示,真菌方面,T1处理显著降低了子囊菌门、青霉属和曲霉属等的相对丰度,增加了腐质霉属和未分类真菌属等的相对丰度;细菌方面,T1处理显著降低了放线菌门、酸杆菌门、67-14属和热酸菌属等的相对丰度,增加了变形菌门、Burkholderia-Caballeronia-Paraburkholderia属和未分类菌属等的相对丰度。土壤理化因子关联性分析显示,pH与酸杆菌门丰度正相关,与担子菌门丰度负相关;有效磷和速效钾含量与担子菌门、放线菌门和芽单胞菌门丰度正相关,与子囊菌门、球囊菌门和绿弯菌门等负相关;有机质含量与变形菌门和芽单胞菌门丰度负相关。研究结果表明Burkholderia sp. SX9能够促进白三叶生长,改善土壤肥力状况,揭示了根际土壤微生物群落结构的动态变化规律,为丰富学科研究内容和土壤改良手段提供了支持。
李春艳, 王钱进, 周芯合, 曹文静, 赵梦丽, 虞方伯. Burkholderia sp. SX9菌剂对白三叶生长和改良土壤的影响[J]. 草业学报, 2025, 34(11): 53-65.
Chun-yan LI, Qian-jin WANG, Xin-he ZHOU, Wen-jing CAO, Meng-li ZHAO, Fang-bo YU. Effects of Burkholderia sp. SX9 inoculants on Trifolium repens growth and soil improvement[J]. Acta Prataculturae Sinica, 2025, 34(11): 53-65.
图1 透射电子显微镜下的菌体形态(a)和LB培养基上的菌落形态(b)
Fig.1 Micrograph of Burkholderia sp. SX9 under transmission electron microscope (a) and photograph of the strain on LB plate (b)

图2 Burkholderia sp. SX9促生特性分析a: 产纤维素分解酶测试平板Cellulolytic enzyme test dish; b: 产蛋白酶测试平板Protease-producing test dish; c: 解钾测试平板Potassium solution test dish; d:产氨测试试管Ammonia production test tube.
Fig.2 Analysis of growth-promoting characteristics of Burkholderia sp. SX9

图3 不同处理对白三叶地上部可溶性糖和可溶性蛋白含量的影响不同小写字母表示差异显著(P<0.05)。Different lowercase letters meant significant difference at 0.05 level.
Fig.3 Effects of different treatments on soluble sugar and soluble protein content in aboveground parts of T. repens
处理 Treatment | 根长 Root length (cm) | 株高 Plant height (cm) | 地上部生物量Aboveground biomass (g·plant-1) | |
|---|---|---|---|---|
| 鲜重Fresh weight | 干重Dry weight | |||
| CK | 19.20±0.59c | 22.43±0.42b | 3.71±0.13cd | 0.52±0.07d |
| T1 | 23.10±0.87a | 26.17±1.34a | 7.52±0.19b | 1.36±0.03b |
| T2 | 20.80±0.89abc | 23.77±0.23ab | 4.34±0.37c | 0.92±0.11c |
| T3 | 20.27±0.09bc | 23.13±1.19b | 3.79±0.42cd | 0.63±0.02d |
| T4 | 21.90±0.75ab | 24.97±0.38ab | 9.23±0.27a | 1.99±0.12a |
| T5 | 20.23±0.52bc | 23.67±0.22ab | 3.72±0.36cd | 0.62±0.13d |
| T6 | 19.77±0.98bc | 22.40±0.96b | 2.86±0.32d | 0.45±0.07d |
表1 不同处理对白三叶不同生长指标的影响
Table 1 Effects of different treatments on various growth indicators of T. repens
处理 Treatment | 根长 Root length (cm) | 株高 Plant height (cm) | 地上部生物量Aboveground biomass (g·plant-1) | |
|---|---|---|---|---|
| 鲜重Fresh weight | 干重Dry weight | |||
| CK | 19.20±0.59c | 22.43±0.42b | 3.71±0.13cd | 0.52±0.07d |
| T1 | 23.10±0.87a | 26.17±1.34a | 7.52±0.19b | 1.36±0.03b |
| T2 | 20.80±0.89abc | 23.77±0.23ab | 4.34±0.37c | 0.92±0.11c |
| T3 | 20.27±0.09bc | 23.13±1.19b | 3.79±0.42cd | 0.63±0.02d |
| T4 | 21.90±0.75ab | 24.97±0.38ab | 9.23±0.27a | 1.99±0.12a |
| T5 | 20.23±0.52bc | 23.67±0.22ab | 3.72±0.36cd | 0.62±0.13d |
| T6 | 19.77±0.98bc | 22.40±0.96b | 2.86±0.32d | 0.45±0.07d |
处理 Treatment | pH | 电导率 EC (μS·cm-1) | 有效磷 Available P (mg·kg-1) | 速效钾 Available K (mg·kg-1) | 碱解氮 Available N (mg·kg-1) | 有机质 Organic matter (g·kg-1) |
|---|---|---|---|---|---|---|
| S | 4.79±0.01e | 44.87±0.24bc | 0.13±0.03c | 37.37±0.89e | 79.06±1.55a | 36.57±0.13b |
| CK | 4.97±0.02c | 31.83±9.37c | 0.24±0.05c | 44.38±0.13d | 66.14±3.20b | 36.05±0.22bc |
| T1 | 5.01±0.03bc | 132.07±0.52a | 4.30±0.17a | 289.44±4.84a | 68.01±5.15ab | 35.33±0.08d |
| T2 | 5.06±0.01a | 48.63±2.52b | 0.24±0.06c | 56.09±0.36c | 78.91±1.37a | 35.51±0.03d |
| T3 | 5.04±0.00ab | 44.00±1.01bc | 0.35±0.03c | 54.97±0.85c | 60.89±3.15b | 35.84±0.06cd |
| T4 | 4.77±0.00e | 126.53±8.43a | 3.38±0.09b | 264.89±2.63b | 71.42±2.37ab | 37.28±0.23a |
| T5 | 4.93±0.01d | 45.27±0.27bc | 0.32±0.05c | 50.01±0.86cd | 77.77±1.30a | 36.26±0.29bc |
| T6 | 5.02±0.02bc | 39.10±0.17bc | 0.28±0.08c | 47.30±0.26d | 66.69±5.94b | 35.81±0.10cd |
表2 不同处理白三叶根际土壤理化性质分析
Table 2 Analysis of physicochemical properties of T. repens rhizosphere soil under different treatments
处理 Treatment | pH | 电导率 EC (μS·cm-1) | 有效磷 Available P (mg·kg-1) | 速效钾 Available K (mg·kg-1) | 碱解氮 Available N (mg·kg-1) | 有机质 Organic matter (g·kg-1) |
|---|---|---|---|---|---|---|
| S | 4.79±0.01e | 44.87±0.24bc | 0.13±0.03c | 37.37±0.89e | 79.06±1.55a | 36.57±0.13b |
| CK | 4.97±0.02c | 31.83±9.37c | 0.24±0.05c | 44.38±0.13d | 66.14±3.20b | 36.05±0.22bc |
| T1 | 5.01±0.03bc | 132.07±0.52a | 4.30±0.17a | 289.44±4.84a | 68.01±5.15ab | 35.33±0.08d |
| T2 | 5.06±0.01a | 48.63±2.52b | 0.24±0.06c | 56.09±0.36c | 78.91±1.37a | 35.51±0.03d |
| T3 | 5.04±0.00ab | 44.00±1.01bc | 0.35±0.03c | 54.97±0.85c | 60.89±3.15b | 35.84±0.06cd |
| T4 | 4.77±0.00e | 126.53±8.43a | 3.38±0.09b | 264.89±2.63b | 71.42±2.37ab | 37.28±0.23a |
| T5 | 4.93±0.01d | 45.27±0.27bc | 0.32±0.05c | 50.01±0.86cd | 77.77±1.30a | 36.26±0.29bc |
| T6 | 5.02±0.02bc | 39.10±0.17bc | 0.28±0.08c | 47.30±0.26d | 66.69±5.94b | 35.81±0.10cd |
处理 Treatment | 真菌Fungus | 细菌Bacterium | ||||
|---|---|---|---|---|---|---|
Chao1指数 Chao1 index | Shannon指数 Shannon index | Simpson指数 Simpson index | Chao1指数 Chao1 index | Shannon指数 Shannon index | Simpson指数 Simpson index | |
| S | 483.31±36.73a | 6.14±0.007a | 0.9659±0.0019a | 4115.56±87.27de | 10.92±0.03a | 0.9989±0.0000a |
| 45 d | ||||||
| CK | 453.67±5.95ab | 5.38±0.006cd | 0.9329±0.0046cde | 4725.57±45.97bc | 10.54±0.04b | 0.9965±0.0001b |
| T1 | 371.52±15.59de | 4.38±0.115g | 0.8338±0.0195g | 3815.45±133.84ef | 9.46±0.10f | 0.9761±0.0030f |
| T2 | 391.15±6.62cd | 5.19±0.001de | 0.9255±0.0010e | 5235.02±207.02a | 10.64±0.09b | 0.9962±0.0005b |
| T3 | 415.22±16.26bc | 5.00±0.110ef | 0.9022±0.0066f | 5028.46±91.21ab | 10.72±0.10b | 0.9971±0.0005b |
| T4 | 438.26±19.20b | 4.86±0.112f | 0.8928±0.0075f | 4165.87±91.16d | 10.01±0.03d | 0.9925±0.0003d |
| T5 | 438.04±3.23b | 5.26±0.007cd | 0.9284±0.0041de | 4517.85±81.49c | 10.63±0.10b | 0.9973±0.0006b |
| T6 | 432.84±12.54bc | 5.44±0.005c | 0.9455±0.0025bcd | 4802.64±146.65bc | 10.66±0.06b | 0.9974±0.0003b |
| 90 d | ||||||
| CK | 422.79±1.87bc | 5.82±0.003b | 0.9497±0.0010abc | 3682.22±92.50f | 10.16±0.09cd | 0.9958±0.0005cd |
| T1 | 331.68±0.85ef | 5.43±0.002c | 0.9367±0.0009cde | 3335.01±122.81g | 9.73±0.09e | 0.9932±0.0006e |
| T2 | 270.76±6.71g | 5.74±0.005b | 0.9593±0.0019ab | 3127.09±107.29gh | 10.20±0.06cd | 0.9972±0.0002cd |
| T3 | 310.53±2.31fg | 5.70±0.003b | 0.9479±0.0014abc | 2995.65±34.85h | 10.16±0.02cd | 0.9972±0.0001cd |
| T4 | 303.74±3.61fg | 5.18±0.003de | 0.9235±0.0019e | 3134.88±47.67gh | 9.50±0.05f | 0.9900±0.0005f |
| T5 | 268.95±18.25g | 5.66±0.005b | 0.9494±0.0008abc | 3794.99±88.12f | 10.32±0.03c | 0.9972±0.0001c |
| T6 | 364.52±4.47de | 6.03±0.001a | 0.9635±0.0003ab | 3670.78±34.53f | 10.30±0.03c | 0.9969±0.0001c |
表3 白三叶根际土壤中真菌与细菌Alpha多样性
Table 3 Alpha diversity of fungi and bacteria in rhizosphere soil of T. repens
处理 Treatment | 真菌Fungus | 细菌Bacterium | ||||
|---|---|---|---|---|---|---|
Chao1指数 Chao1 index | Shannon指数 Shannon index | Simpson指数 Simpson index | Chao1指数 Chao1 index | Shannon指数 Shannon index | Simpson指数 Simpson index | |
| S | 483.31±36.73a | 6.14±0.007a | 0.9659±0.0019a | 4115.56±87.27de | 10.92±0.03a | 0.9989±0.0000a |
| 45 d | ||||||
| CK | 453.67±5.95ab | 5.38±0.006cd | 0.9329±0.0046cde | 4725.57±45.97bc | 10.54±0.04b | 0.9965±0.0001b |
| T1 | 371.52±15.59de | 4.38±0.115g | 0.8338±0.0195g | 3815.45±133.84ef | 9.46±0.10f | 0.9761±0.0030f |
| T2 | 391.15±6.62cd | 5.19±0.001de | 0.9255±0.0010e | 5235.02±207.02a | 10.64±0.09b | 0.9962±0.0005b |
| T3 | 415.22±16.26bc | 5.00±0.110ef | 0.9022±0.0066f | 5028.46±91.21ab | 10.72±0.10b | 0.9971±0.0005b |
| T4 | 438.26±19.20b | 4.86±0.112f | 0.8928±0.0075f | 4165.87±91.16d | 10.01±0.03d | 0.9925±0.0003d |
| T5 | 438.04±3.23b | 5.26±0.007cd | 0.9284±0.0041de | 4517.85±81.49c | 10.63±0.10b | 0.9973±0.0006b |
| T6 | 432.84±12.54bc | 5.44±0.005c | 0.9455±0.0025bcd | 4802.64±146.65bc | 10.66±0.06b | 0.9974±0.0003b |
| 90 d | ||||||
| CK | 422.79±1.87bc | 5.82±0.003b | 0.9497±0.0010abc | 3682.22±92.50f | 10.16±0.09cd | 0.9958±0.0005cd |
| T1 | 331.68±0.85ef | 5.43±0.002c | 0.9367±0.0009cde | 3335.01±122.81g | 9.73±0.09e | 0.9932±0.0006e |
| T2 | 270.76±6.71g | 5.74±0.005b | 0.9593±0.0019ab | 3127.09±107.29gh | 10.20±0.06cd | 0.9972±0.0002cd |
| T3 | 310.53±2.31fg | 5.70±0.003b | 0.9479±0.0014abc | 2995.65±34.85h | 10.16±0.02cd | 0.9972±0.0001cd |
| T4 | 303.74±3.61fg | 5.18±0.003de | 0.9235±0.0019e | 3134.88±47.67gh | 9.50±0.05f | 0.9900±0.0005f |
| T5 | 268.95±18.25g | 5.66±0.005b | 0.9494±0.0008abc | 3794.99±88.12f | 10.32±0.03c | 0.9972±0.0001c |
| T6 | 364.52±4.47de | 6.03±0.001a | 0.9635±0.0003ab | 3670.78±34.53f | 10.30±0.03c | 0.9969±0.0001c |

图4 真菌群落门分类水平相对丰度分析Asc: 子囊菌门Ascomycota; Basi: 担子菌门Basidiomycota; Mor: 被孢霉门Mortierellomycota; Chy: 壶菌门Chytridiomycota; Kic: 梳霉门Kickxellomycota; Roz: 罗兹菌门Rozellomycota; Glo: 球囊菌门Glomeromycota; Muc: 毛霉门Mucoromycota; Bas: 蛙粪菌门Basidiobolomycota; Others: 未分类菌门Unclassified fungal phyla.
Fig.4 Relative abundance analysis of fungal community at phylum level

图5 真菌群落属分类水平相对丰度分析Hum: 腐质霉属Humicola; Sai: Saitozyma; Fus: 镰刀菌属Fusarium; Alt: 交链孢属Alternaria; Tri: 木霉属Trichoderma; Pen: 青霉属Penicillium; Asp: 曲霉属Aspergillus; Sol: 隐球酵母属Solicoccozyma; Cla: 枝孢属Cladosporium; Tal: 蓝状菌属Talaromyces; Mel: Melanconiella; Knu: Knufia; Sta: Staphylotrichum; Pur: 淡紫拟青霉属Purpureocillium; Others: 未分类真菌属Unclassified fungal genera.
Fig.5 Relative abundance analysis of fungal community at genus level

图6 细菌群落门分类水平相对丰度分析Act: 放线菌门Actinobacteriota; Pro: 变形菌门Proteobacteria; Aci: 酸杆菌门Acidobacteriota; Chl: 绿弯菌门Chloroflexi; Ver: 疣微菌门Verrucomicrobiota; Gem: 芽单胞菌门Gemmatimonadota; Fir: 厚壁菌门Firmicutes; Myx: 粘球菌门Myxococcota; Bac: 拟杆菌门Bacteroidota; Others: 未分类细菌门Unclassified bacterial phylum.
Fig.6 Relative abundance analysis of bacterial community at phylum level

图7 细菌群落属分类水平相对丰度分析Bur: Burkholderia-Caballeronia-Paraburkholderia; Sph: 鞘氨醇单胞菌属Sphingomonas; Gem: 芽单胞菌属Gemmatimonas; Bac: 芽孢杆菌属Bacillus; Aci: 热酸菌属Acidothermus; Str: 链霉菌属Streptomyces; Ram: 拉姆利杆菌属Ramlibacter; Mas: 马赛菌属Massilia; Can: Candidatus-Udaeobacter; Gai: 盖亚菌属Gaiella; Noc: 诺卡氏菌属Nocardioides; Con: 束缚菌属Conexibacter; Others: 未分类细菌属Unclassified bacterial genus.
Fig.7 Relative abundance analysis of bacterial community at genus classification level

图8 90 d时根际土壤微生物群落相对丰度与土壤理化因子关联性分析AP: 有效磷Available phosphorus; AK: 速效钾Available potassium; OM: 有机质Organic matter; AN: 碱解氮Available nitrogen; 图中所示为相对丰度排名前9菌门(不含未分类菌门)数据(每个处理3个重复)The figure shows the data of the top nine phyla (excluding unclassified phyla) in relative abundance (three replicates per treatment); *: P<0.05, **: P<0.01, ***: P<0.001.
Fig.8 Correlation analysis of relative abundance of rhizosphere soil microbial communities and soil physicochemical factors at 90 d
| [1] | Ministry of Agriculture and Rural Affairs. Announcement of national arable land quality grading in 2019. Gazette of the Ministry of Agriculture and Affairs of the People’s Republic of China, 2020(4): 113-121. |
| 农业农村部. 2019年全国耕地质量等级情况公报. 中华人民共和国农业农村部公报, 2020(4): 113-121. | |
| [2] | Kong X B, Chen W G, Dang Y X. Current situation, challenges and transformation of cultivated land protection in China. Journal of Social Science of Hunan Normal University, 2023, 52(5): 31-41. |
| 孔祥斌, 陈文广, 党昱譞. 中国耕地保护现状、挑战与转型. 湖南师范大学社会科学学报, 2023, 52(5): 31-41. | |
| [3] | Tang Z G. The application and research progress of earthworms in ecological agriculture in China. Modern Rural Science and Technology, 2023(6): 95-96. |
| 汤宗光. 蚯蚓在我国生态农业中的应用及研究进展. 现代农村科技, 2023(6): 95-96. | |
| [4] | He S R, Liu X J, Zhao Y J, et al. Effects of alfalfa/sweet sorghum intercropping on rhizosphere soil characteristics and microbial community characteristics. Acta Prataculturae Sinica, 2024, 33(5): 92-105. |
| 何升然, 刘晓静, 赵雅姣, 等. 紫花苜蓿/甜高粱间作对根际土壤特性及微生物群落特征的影响. 草业学报, 2024, 33(5): 92-105. | |
| [5] | Wu Q C, Chen Y, Dou X H, et al. Microbial fertilizers improve soil quality and crop yield in coastal saline soils by regulating soil bacterial and fungal community structure. The Science of the Total Environment, 2024, 949: 175127. |
| [6] | Xiang C Y, Luo D Y, Guo L, et al. Advances in plant-microbial combined remediation of chemically-degraded soils. Chinese Journal of Soil Science, 2024, 55(1): 288-300. |
| 向春雨, 罗栋源, 郭莉, 等. 植物-微生物联合修复化学退化土壤研究进展. 土壤通报, 2024, 55(1): 288-300. | |
| [7] | Wei Y L, Yang H, Hu J D, et al. Trichoderma harzianum inoculation promotes sweet sorghum growth in the saline soil by modulating rhizosphere available nutrients and bacterial community. Frontiers in Plant Science, 2023, 14: 1258131. |
| [8] | El-Amriti F A, Ouf S A, Abu-Elghait M, et al. Alleviation of salt stress on Zea mays L. plant by PGPR isolates as an effective sustainable strategy. Biocatalysis and Agricultural Biotechnology, 2024, 61: 103346. |
| [9] | Ma B G, Wei X H, Meng X J, et al. Advancements in study on Burkholderia for plant disease biocontrol. Agricultural Research and Application, 2023, 36(3): 1-8. |
| 马白鸽, 魏喜红, 孟祥佳, 等. 伯克霍尔德氏菌在植物病害生物防治中的研究进展. 农业研究与应用, 2023, 36(3): 1-8. | |
| [10] | Naveed M, Mitter B, Reichenauer G T, et al. Increased drought stress resilience of maize through endophytic colonization by Burkholderia phytofirmans PsJN and Enterobacter sp. FD17. Environmental and Experimental Botany, 2014, 97: 30-39. |
| [11] | Sun Z X, Meng X J, Long X Y, et al. Control effect and growth-promoting effect of Burkholderia YZU-S230 on watermelon fusarium wilt. Journal of Yangtze University (Natural Science Edition), 2021, 18(2): 82-88. |
| 孙正祥, 孟祥佳, 龙欣钰, 等. 伯克霍尔德氏菌YZU-S230对西瓜枯萎病的防效及其促生作用. 长江大学学报(自然科学版), 2021, 18(2): 82-88. | |
| [12] | Wang Y J, Liu L, Hu Y, et al. The spatio-temporal change in soil P and P-solubilizing bacteria under clover mulching in apple orchards of Loess Plateau. Chemosphere, 2022, 304: 135334. |
| [13] | Wang Y J, Huang W, Li Y Q, et al. Isolation, characterization, and evaluation of a high-siderophore-yielding bacterium from heavy metal contaminated soil. Environmental Science and Pollution Research International, 2021, 29(3): 3888-3899. |
| [14] | Xie H P, Lin Y T, Wu X Y, et al. Screening and identification of biocontrol bacteria of cowpea Fusarium wilt and preliminary exploration of disease resistance mechanism. Chinese Journal of Tropical Crops, 2023, 44(6): 1224-1236. |
| 谢海鹏, 林樱桃, 吴小燕, 等. 豇豆枯萎病生防细菌的筛选鉴定及抗病机理初探. 热带作物学报, 2023, 44(6): 1224-1236. | |
| [15] | Bao S D. Soil agricultural analysis. Beijing: China Agriculture Press, 2000. |
| 鲍士旦. 土壤农化分析. 北京: 中国农业出版社, 2000. | |
| [16] | Cui G W. Effect of low temperature stress on soluble sugar and starch of alfalfa at germination period. Journal of Northeast Agricultural University, 2009, 40(1): 72-76. |
| 崔国文. 低温胁迫对紫花苜蓿种子萌发期可溶性糖和淀粉的影响. 东北农业大学学报, 2009, 40(1): 72-76. | |
| [17] | Chen Y Q, Liu J Y, Liu W K, et al. Effects of LED red and blue light intensity on the growth, yield and quality of Medicago sativa. Chinese Journal of Grassland, 2023, 45(8): 23-30. |
| 陈艳琦, 刘家源, 刘文科, 等. LED红蓝光光强对紫花苜蓿生长产量与品质的影响. 中国草地学报, 2023, 45(8): 23-30. | |
| [18] | Ge J Z, Fu W H, Zhang L, et al. Degradation of carbendazim in orchard white clover silage and its effect on the microbial fermentative community. Acta Prataculturae Sinica, 2022, 31(7): 64-75. |
| 戈建珍, 傅文慧, 张露, 等. 多菌灵在果园白三叶青贮中的降解及其对微生物群落的影响. 草业学报, 2022, 31(7): 64-75. | |
| [19] | Liu X G, Li N, Ji T, et al. Effects of microbial agents and corn protein ferment on physiological characteristics in leaves and yield of tomato. Chinese Journal of Applied Ecology, 2023, 34(11): 3039-3044. |
| 刘希港, 李楠, 季托, 等. 微生物菌剂和玉米蛋白酵素对番茄叶片生理特性和产量的影响. 应用生态学报, 2023, 34(11): 3039-3044. | |
| [20] | Li Z Q, Liu P Y, Zhang Y, et al. Effects of inoculant application at different stages on tomato growth, quality and expression of related enzyme gene. Northern Horticulture, 2023(4): 1-8. |
| 李正青, 刘朋宇, 张颖, 等. 不同时期施用菌剂对番茄生长、品质及相关酶基因表达. 北方园艺, 2023(4): 1-8. | |
| [21] | Gao Z L, Zhu J J, Juan J X, et al. Effects of compound fertilizer combined with microbial agent on growth of Cerasus campanulata ‘Feihan’ seedlings. Acta Agriculturae Shanghai, 2021, 37(5): 116-120. |
| 高照亮, 朱建军, 隽加香, 等. 复合肥配施微生物菌剂对‘飞寒樱’苗木生长影响效果研究. 上海农业学报, 2021, 37(5): 116-120. | |
| [22] | Lyu L Y, Duan G Z, Su C F, et al. Effects of microbial agents on growth and soil properties of Lycium barbarum L. Journal of Shenyang Agricultural University, 2022, 53(4): 476-482. |
| 吕亮雨, 段国珍, 苏彩风, 等. 木霉菌微生物菌剂对枸杞生长及土壤性状的影响. 沈阳农业大学学报, 2022, 53(4): 476-482. | |
| [23] | Li J H, Gao K X, Wan L, et al. Effects of microbial agent on the growth of Catalpa bungei seedlings and the diversity of bacterial community in rhizosphere soil. Acta Ecologica Sinica, 2020, 40(21): 7588-7601. |
| 李金花, 高克祥, 万利, 等. 微生物菌剂对楸树幼苗生长及根际土细菌群落结构的影响. 生态学报, 2020, 40(21): 7588-7601. | |
| [24] | Ling N, Wang T T, Yakov K. Rhizosphere bacteriome structure and functions. Nature Communications, 2022, 13(1): 836. |
| [25] | Wang Y Q, Yuan C X, Yue K, et al. Meta-analysis of plant restoration impacts on soil microbial community structure in mining areas. Chinese Journal of Applied Ecology, 2024, 35(4): 1141-1149. |
| 王译庆, 袁朝祥, 岳楷, 等. 植被恢复对矿区土壤微生物群落结构影响的整合分析. 应用生态学报, 2024, 35(4): 1141-1149. | |
| [26] | Wang Z F, Li Y, Zhang Q Y, et al. Effect of microbicides on main diseases and soil microbial communities of tomatoes in facilities. Journal of Agricultural Science and Technology, 2024, 26(6): 102-112. |
| 王子凡, 李燕, 张庆银, 等. 微生物菌剂对设施番茄主要病害及土壤微生物群落的影响. 中国农业科技导报, 2024, 26(6): 102-112. | |
| [27] | Xian K H, Su J, Fu C M, et al. Effects of different bacterial fertilizers on microbial diversity, physical and chemical properties of rhizosphere soil of Paris polyphylla var. chinensis. Guangxi Sciences, 2021, 28(6): 616-625. |
| 冼康华, 苏江, 付传明, 等. 不同菌肥对华重楼根际土壤微生物多样性及理化性质的影响. 广西科学, 2021, 28(6): 616-625. | |
| [28] | Wen S F, Jiang R H, Zhu C Q, et al. Effects of phosphate-solubilizing bacteria on the rhizosphere soil properties and microbial community structure of maize in lead-contaminated soil. Biotechnology Bulletin, 2024, 40(9): 225-237. |
| 温绍福, 江润海, 朱城强, 等. 铅污染土壤中解磷菌对玉米根际土壤性质和微生物群落结构的影响. 生物技术通报, 2024, 40(9): 225-237. | |
| [29] | Wang D, Li X Y, Lu H, et al. Effects of facility vegetable cultivation on soil microbial community structure and microbial interactions. South-Central Agricultural Science and Technology, 2024, 45(11): 13-22. |
| 王丹, 李心怡, 卢涵, 等. 设施蔬菜栽培对土壤微生物群落结构及微生物互作的影响. 中南农业科技, 2024, 45(11): 13-22. | |
| [30] | Egidi E, Delgado-Baquerizo M, Plett J M, et al. A few Ascomycota taxa dominate soil fungal communities worldwide. Nature Communications, 2019, 10(1): 1-9. |
| [31] | Wan W J, Tan J D, Wang Y, et al. Responses of the rhizosphere bacterial community in acidic crop soil to pH: Changes in diversity, composition, interaction, and function. Science of the Total Environment, 2020, 700: 134418. |
| [32] | Li X F, Deng S P, Raun W R, et al. Bacterial community in soils following century-long application of organic or inorganic fertilizers under continuous winter wheat cultivation. Agronomy, 2020, 10(10): 1497. |
| [33] | Justin F, Khalil W, Maxime H, et al. Native bacterial communities and Listeria monocytogenes survival in soils collected from the lower mainland of British Columbia, Canada. Canadian Journal of Microbiology, 2018, 64(10): 695-705. |
| [34] | Gao F, Wen S Z, Wei S X, et al. Effect of vegetation restoration models on soil physiochemical properties, enzymes activities and fungal diversity in rocky desertification area of northwest Guangxi, China. Acta Agriculturae Zhejiangensis, 2023, 35(10): 2425-2435. |
| 高风, 文仕知, 韦铄星, 等. 桂西北石漠化区不同植被恢复类型对土壤理化性质、酶活与真菌群落多样性的影响. 浙江农业报, 2023, 35(10): 2425-2435. | |
| [35] | Zheng X W, Dai X, Zhu Y X, et al. (Meta) Genomic analysis reveals diverse energy conservation strategies employed by globally distributed Gemmatimonadota. mSystems, 2022, 7(4): e0022822. |
| [1] | 罗叙, 马慧, 韩翠, 赵雅欣, 赵莹, 谢应忠, 李建平. 地上净初级生产力对植物物种丰富度的响应及影响因子分析[J]. 草业学报, 2025, 34(9): 26-37. |
| [2] | 马红钰, 周小国, 王宝, 宋渝川, 艾克热木·阿不拉提江null, 蒋邵丽, 闵九洲, 赵红梅, 程军回. 准噶尔荒漠梭梭和柽柳根际土壤微生物功能基因丰度变化特征[J]. 草业学报, 2025, 34(8): 109-122. |
| [3] | 张琨, 乔建霞, 李金升, 王育鹏, 刘克思. 不同修复材料对退化高寒草地土壤理化性质及微生物群落的影响[J]. 草业学报, 2025, 34(8): 132-148. |
| [4] | 汤珊珊, 胡敏. 禾本科植物根际土壤酶活性和细菌群落结构差异[J]. 草业学报, 2025, 34(8): 99-108. |
| [5] | 王颖, 李明源, 麦日艳古·亚生null, 王继莲. 新疆托木尔峰不同植物根际土壤真菌群落结构比较研究[J]. 草业学报, 2025, 34(7): 83-94. |
| [6] | 邓文辉, 宋珂辰, 张浩, 管思雨, 雍嘉仪, 胡海英. 降水变化条件下荒漠草原优势植物根际微生物群落结构和多样性特征研究[J]. 草业学报, 2025, 34(5): 12-26. |
| [7] | 涂晓东, 崔俊芳, 况福虹, 李春培, 杜玖珍, 王红兰, 唐翔宇. 川西北高寒草甸转为耕地对土壤微生物群落的影响[J]. 草业学报, 2025, 34(2): 54-66. |
| [8] | 秦晓芳, 何芷睿, 贾彤, 杨玉娇, 付薇, 李航, 彭燕. 白三叶几丁质酶基因家族鉴定及TrChit3功能分析[J]. 草业学报, 2025, 34(10): 187-201. |
| [9] | 李争艳, 徐智明, 李岩, 李杨. 江淮地区苜蓿短期连作对后作高丹草生长及土壤微环境的影响[J]. 草业学报, 2024, 33(9): 155-168. |
| [10] | 伍国强, 于祖隆, 魏明. PGPR调控植物响应逆境胁迫的作用机制[J]. 草业学报, 2024, 33(6): 203-218. |
| [11] | 何升然, 刘晓静, 赵雅姣, 汪雪, 王静. 紫花苜蓿/甜高粱间作对根际土壤特性及微生物群落特征的影响[J]. 草业学报, 2024, 33(5): 92-105. |
| [12] | 程鑫宇, 王继莲, 麦日艳古·亚生null, 李明源. 盐爪爪根际土壤产IAA菌株分离及促生特性分析[J]. 草业学报, 2024, 33(4): 110-121. |
| [13] | 马源, 王晓丽, 马玉寿, 张德罡. 高寒草甸退化程度对优势物种根际土壤真菌群落和生态网络的影响[J]. 草业学报, 2024, 33(2): 125-137. |
| [14] | 邢静, 范文强, 王佳妮, 石凤翎. 干旱胁迫下 2个扁蓿豆品种根际细菌多样性及土壤灭菌对其生长的影响[J]. 草业学报, 2024, 33(12): 147-159. |
| [15] | 张许可, 夏红飞, 陈国立, 李德州, 张晓伟, 李克梅, 王丽丽. 白三叶草镰刀菌根腐病病原鉴定及其生物学特性[J]. 草业学报, 2024, 33(12): 175-187. |
| 阅读次数 | ||||||
|
全文 |
|
|||||
|
摘要 |
|
|||||